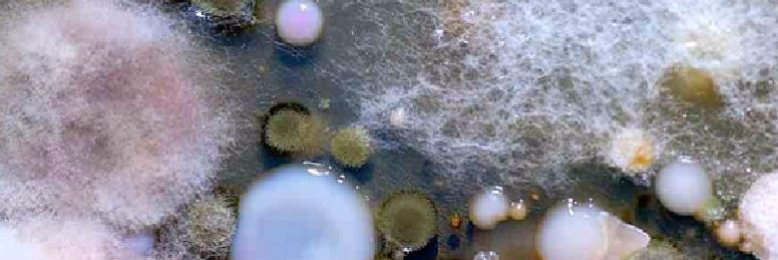
Cover image for post Daily Experiment, by DaveScott

The Old Gods.
The march toward God is endless. We were created by our alien gods, so too were they created by theirs. Beings of immense power, and unbelievable intellect. The ants look to us and see giants, so too do we look towards the heavens. The endlessness of the cosmos houses the hosts of heaven, whom the bible deems "angels" or "demons." now, in our day and age, we know them as extraterrestrial life forms. And these "e.t.s," as we have dubbed them, have their own gods. Cruel, unforgiving. The Old Gods. Bringers of destruction and the doom of humanity.
If aliens created us... Then who created the aliens? Well there is a paradoxical solution to this question. The answer is US. That's right WE created aliens. No one knows this except for me and my family. We hold it a secret. The humans that created these aliens are now extinct. They were once called jaonians. They used the power of the earth to bring powerful helpers. But the aliens turned on them and eliminated them... Leaving only us.
Daily Experiment
Merv walked up to Derv’s desk as he was peeking into his quint-micronoscope, “still progressing?”
Slightly startled, “um, not as we originally hoped.”
Tilting his bulbous head from his clipboard blinking his five non-uniform eyes, “oh… why…?”
“Well those little Grey dudes we manufactured yesterday with the…?”
“Yeah only two eyes… well what?”
A little shaken, “oh yes well they did what we bio-programmed them for and planted other bipeds on a subsystem.”
“And…?”
“Well the subspecies they created are advancing but seem to enjoy killing each other, so…”
“Yeah who doesn’t,” walking away uninterested, “flush it all, start over…”
Ridiculous Conspiracy?
T- mobile has this back room where they create men. I sat in the waiting area and saw studs in uniform, clean shaved and ready to work. New men exiting the break room. This batch of men resembled each other in their appearance. It could be a technology malfunction but pleasant to the eye.
Truth is the aliens were created by companies such as T-mobile. Aliens are simple workers in charge of design and sculpting. They created us to produce and consume the products sold by companies in order to create larger and greater companies through our work and consumption.
LOL
The illuminati created the aliens. Illuminati is everyone, everything and all. It's Obama, warm milk and fruit loops. It's the letter G, a guitar and Uranium. Illuminati is all, see's all. He is disguised as the dairy queen mascot mouth because he hides his eye. Beware of Illuminati. I am Illuminati.
The Angels
Everyone knows we came from them.
The Angels, I mean.
Made in one of their experiments.
They crafted us because they were lonely.
They lost their homeland and set into the heavens.
They hoped we would make earth ready for them.
They made a perfect place and we ruined it.
They moved on.
The Angels left, I mean.
Now we set out in space, we lost our homeland.
We will make new creatures because, as we die slowly,
We will become more lonely.
But who made them?
Is this just a long cycle?
Are we the Angels now, I mean.
The Answer to the Universe
Untangling the web of begetting is an insurmountable task. We created clones and drones. We were created by a long-lost and long-bored-to-death species. Our greatest minds sought to find out what came before; to answer the question that had no purpose. They tugged the strands of life and as it unraveled, its end point startled us.
Who had created us all? No one. Life was never the work of a genius; it was far too nonsensical for that. Our creators were the result of the universe’s tantrum. Two rocks with lichen smashed together. Childs of chance.
Boredom Doesn’t Kill, It Creates
It should never have happened. It shouldn't have been possible. But that didn't change the facts. Doctor Raymond Niesen-Ward had been bored. Horrendously bored. They'd made leaps and bounds in recent years, realised that there was no way that humans had just evolved. They had to have been created. And they'd found evidence of who had created them. The only problem? They didn't know who'd created the aliens.
In Raymond's defense, he was really bored, and they had a time-travel machine they'd wanted to test.
He'd never thought he would end up creating the creators.
You’d rather not know
The aliens are much like processed junk food, cheap "fast fashion" clothes, and Apple products, at least in one respect: it's much easier to be happy about them if you try to forget under what circumstances and by whom they were created.
If confronted with the truth, I recommend responding as you would to information about unappetizing additives, sweatshops, and suicide nets: simply plug your ears, close your eyes, and shout "la la la I can't hear youuuuuuu" until the person disturbing your blissful ignorance kindly shuts up and goes and fucks himself (which, incidentally, is how the aliens reproduce).